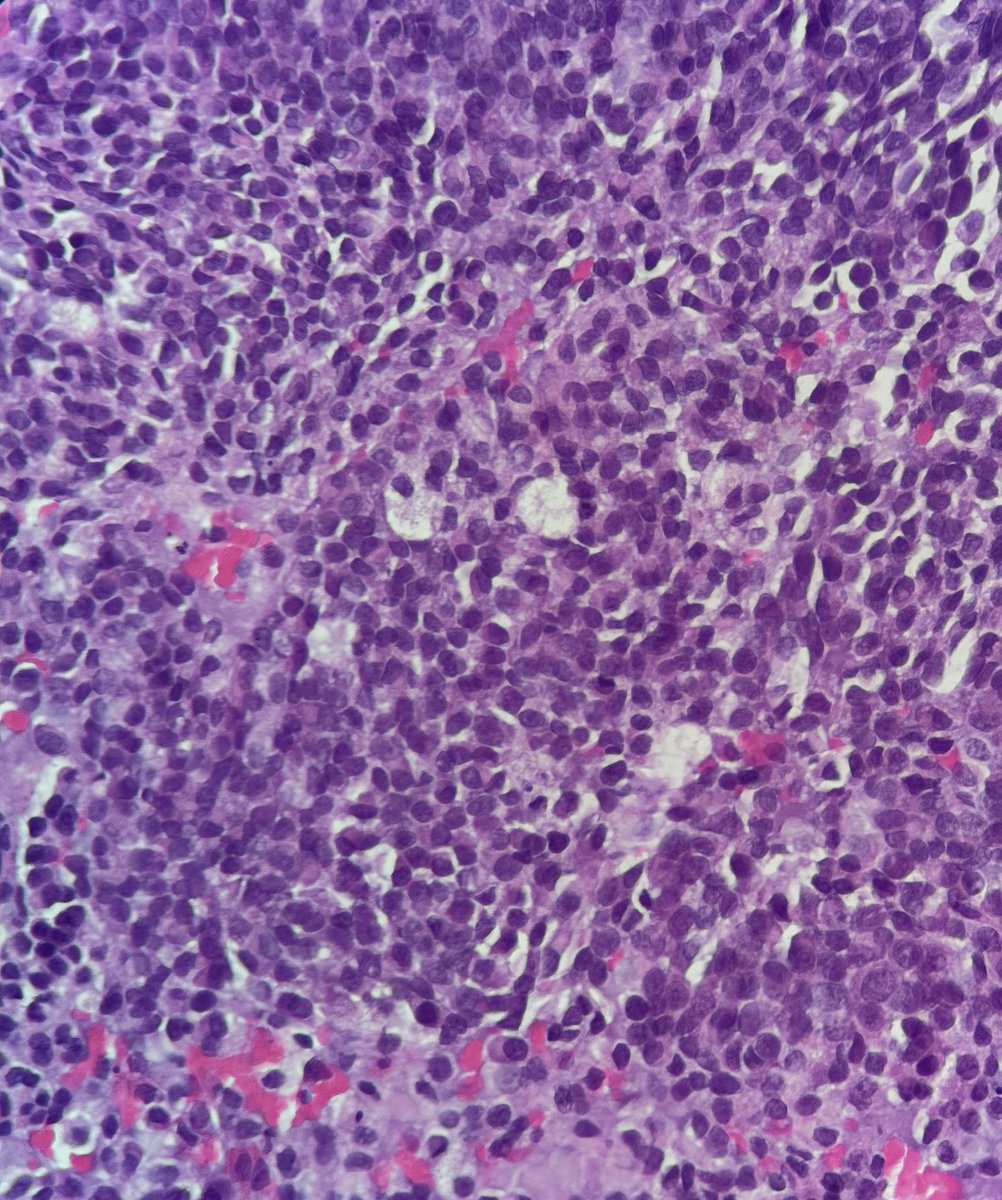
Bruno Sedassari, DMD, PhD tweet media

J. Bish
514 posts



Officially signed to continue my academic and baseball career at SAU Tech
Grateful for everyone who helped me get here, ready to get to work #Signed #Committed @TCSPostGrad @SAUT_BSB


English
J. Bish retweetet

Attending #USCAP26?
Don't miss @PulmPathSoc Companion Mtg featuring the all-star cast:
Justin Bishop, Andres Acosta, Rex Hung, Jenn Boland: aka #pathology Avengers. No diagnosis left unsolved!
[flier brainchild of Susan Armstrong+AI]
Delighted to have organized this session!


English
J. Bish retweetet

⚾BASEBALL:
After a Friday split, the Eutectics and Mustangs finish out their three-game AMC series today at 1:00p.
📺tinyurl.com/2rhb856k
#UHSPAthletics #GoEuts #TheRightWayToPlay

English

UHSP announces agreement with @WashU to acquire its campus and St. Louis College of Pharmacy.
Learn more at uhsp.edu/announcement
English
J. Bish retweetet

Novel Glomeruloid Adenocarcinoma Arising in the Mandible Harboring EWSR1::YY1
Daniel L. Miller, Justin A. Bishop & Louis P. Dehner
rdcu.be/eXlPZ
#HeadNeckPathol #HNPJ #HeadandNeckPath #Pathology #ENTPath #PathologyTweet


English
J. Bish retweetet

Just out in AJSP – a paper from our group describing a MAJOR new oddity.
Tumors that normally arise in the jaw from tooth🦷precursors (ameloblastoma) – but as lung primaries 🫁!
This was a neat collaboration b/w MSKCC, Mayo and UTSW where these cases were encountered independently, and we put our heads together with the help of original contributors and fellows to tackle this puzzle.
Time will tell if these are truly exceptional or have been underrecognized.
journals.lww.com/ajsp/fulltext/…
@JLHornick @ENTpathology @MSKPathology @PulmPathSoc @yro854 @thoracicpath @Path_Matt @SansanoValero @AndreMo77438628




English
J. Bish retweetet

From arppress.org/books/book/67:
Nuchal-type fibroma is a benign, highly collagenized soft tissue tumor that occurs primarily in the posterior neck, paraspinal, and interscapular regions of adults. Almost 50% of reported patients have had diabetes.
#ENTpath #HNpath

English
J. Bish retweetet

Happy August! More from (arppress.org/books/book/67):
Low-grade nasopharyngeal papillary adenocarcinoma (LGNPA) shows a papillary growth pattern and is associated with an indolent biologic behavior. These are TTF1 positive!
#ENTpath #HNpath

English
J. Bish retweetet

Our Newest Fascicle is Now Available at arppress.org
Become a Subscriber and Save! (Subscriber form here: buff.ly/lzCOC0L)

English
J. Bish retweetet

Hot off the press from arppress.org/books/book/67:
Embryonal rhabdomyosarcoma (RMS) is the most common type of RMS of the head and neck; submucosal tumors classically display a “cambium zone” of increased cellularity immediately below the epithelium.
#ENTpath #HNpath #BSTpath

English
J. Bish retweetet

.@McK_Marshals Collegiate Black’s Riley Bishop (@_Riley_11_) smokes the pitch back up the middle for a single.
@UHSPBaseball
Profile: fivetool.org/players/984468…
English
J. Bish retweetet

A preview from the new Series 5 fascicle: Tumors of the Upper Aerodigestive Tract, Ear, and Jaw (arppress.org/books/book/67):
Granular cell tumor is a benign neuroectodermal tumor that can be accompanied by overlying pseudoepitheliomatous hyperplasia (second image set; not to be mistaken for squamous cell carcinoma). More than 50% of cases of granular cell tumor involve the head & neck!
#ENTpath #HNpath


English
J. Bish retweetet

We're so excited for this! Stay tuned, coming soon.
WC Faquin, MD, PhD@bfaquin
Coming soon! Can’t wait! 😜
English
J. Bish retweetet

.@McK_Marshals Collegiate Black’s Riley Bishop (@_Riley_11_) rockets one to left for a single.
@UHSPBaseball
Profile: fivetool.org/players/984468…
English

@TheVoiceofTD @Thatmandko21 @CHS_CowboysBB @CoppellSports1 Thanks for all your nice words about Riley 😀
English
J. Bish retweetet

The “Archbishop” (as @Thatmandko21 called him) was a human highlight reel. Congrats, Riley! #txhsbaseball @CHS_CowboysBB @CoppellSports1
Coppell Cowboys Baseball@CHS_CowboysBB
Congratulations to @CHS_CowboysBB senior outfielder @_Riley_11_ for earning District 5-6A Second Team All District Outfield!
English
J. Bish retweetet

Congratulations to @CHS_CowboysBB senior outfielder @_Riley_11_ for earning District 5-6A Second Team All District Outfield!

English

59-year-old woman with a destructive sinonasal tumor. Liver and iliac mets on CT. Biopsy performed (more pics below). Diagnostic opinions are welcome! #pathology #PathTwitter #surgicalpath #oralpath #entpath




English